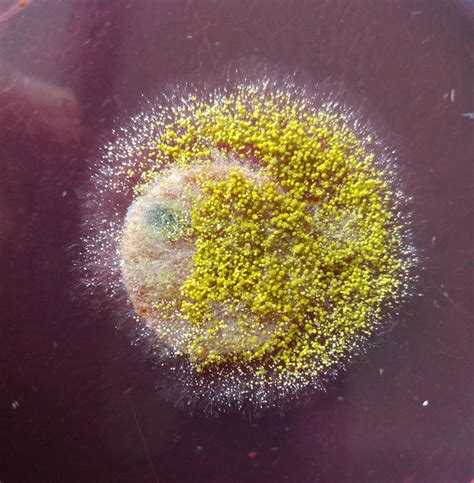
aspergillus flavus mold xperts

Jika kamu sedang mencari Aspergillus Flavus, maka anda berada di halaman yang tepat. Kami menyediakan aneka Aspergillus Flavus yang bisa anda pesan online. Silakan hubungi kami via +6282245078486, jangan lupa sertakan juka gambar yang diinginkan.
Kami mengirim paket Aspergillus Flavus melalui berbagai ekspedisi, misalnya JNE, JNT, POS, dll. Kami juga menerima pembayaran via BCA/Mandiri/dll. Pengiriman biasanya tidak sampai seminggu sudah sampai dan kami sertakan pula nomor resi yang bisa digunakan untuk tracking barang secara online.

Tidak hanya Aspergillus Flavus, anda juga bisa melihat gambar lain seperti
Colony Morphology,
Under Microscope,
Aerial Hyphae,
Paddy Plant,
Gambar Mikroskop,
Microscope Drawing,
En Yogurt,
SoyBean,
Sabouraud Agar,
White Mold,
and Hyphae Under Microscope.
Berbagai Contoh Aspergillus Flavus
Berikut kami sertakan berbagai contoh gambar untuk Aspergillus Flavus, silakan save gambar di bawah dengan klik tombol pesan, anda akan kami arahkan pemesanan via WA ke +6282245078486.
 768×1024
768×1024
aspergillus flavus morfologi klasifikasi peran ekologis jamur
Order Sekarang
 567×554
567×554
aspergillus flavus alchetron social encyclopedia
Order Sekarang
 1939×1928
1939×1928
aspergillus flavus mycology culture collection
Order Sekarang
 589×800
589×800
fungus aspergillus flavus stock image science photo library
Order Sekarang
 1024×576
1024×576
aspergillus flavus introduction morphology pathogenicity lab diagnosis
Order Sekarang
 1920×1080
1920×1080
aspergillus flavus overview biology notes reference articles
Order Sekarang
 735×491
735×491
aspergillus flavus stock photo getty images stock photo
Order Sekarang
 1300×1120
1300×1120
aspergillus flavus res stock photography images alamy
Order Sekarang
 1426×697
1426×697
aspergillus flavus facesoffungi number fof faces fungi
Order Sekarang
 763×645
763×645
gambar perbandingan penampilan pertumbuhan antara aspergillus flavus
Order Sekarang
 783×734
783×734
aspergillus flavus morphologic molecular metabolic
Order Sekarang
 638×638
638×638
macroscopic microscopic features aspergillus flavus
Order Sekarang
 474×474
474×474
aspergillus flavus institut national de sante publique du quebec
Order Sekarang
 320×320
320×320
aspergillus flavus phenotypes colonies grown sda
Order Sekarang
 850×637
850×637
microscopical examination aspergillus flavus strains
Order Sekarang
 650×329
650×329
aspergillus flavus definition structure characteristics habitat
Order Sekarang
1150×1588
1150×1588
figure molecular characterization aspergillus flavus
Order Sekarang
Temukan solusi terbaik untuk kenyamanan ruang Anda dengan Aspergillus Flavus! Produk peredam suara dan panas ini menawarkan performa maksimal dengan harga yang terjangkau. Dapatkan kualitas unggul tanpa menguras kantong, dan nikmati suasana tenang serta sejuk di setiap sudut rumah atau kantor Anda. Pilih Aspergillus Flavus – pilihan cerdas untuk investasi jangka panjang!
Maaf, tidak ada yang cocok dengan kriteria yang Anda cari.
Apa yang ingin Anda lakukan?
« kembali ke Beranda atau gunakan kotak pencarian dibawah ini untuk mulai penelusuran baru.









